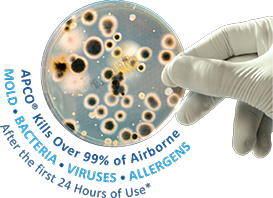

Call Today
1-866-DORAL-55
1-866-367-2555

Call Today
1-866-DORAL-55
1-866-367-2555

1-305-632-6055

Business Hours:
Mon - Fri: 8AM-9PM
Sat & Sun: 8AM-6PM
Servicing the City of Doral, FL
Protect your family from:
ALLERGENS, GERMS, MOLD, ODORS & VIRUSES
WITH OUR WHOLE-HOUSE PURIFIER!
We proudly install the Best solution for your indoor air quality...
A Small Step For You, A Giant Leap For Your Family Health

Detox the Air!
The APCO system (Advanced Photocatalytic Oxidation) represents an entirely new type of air purifier. APCO is installed in the ductwork of the central air system where it scrubs the air as is passes by. APCO's unique combination of UV-C light and activated carbon achieves unmatched germ and odor reduction without producing any harmful ozone. APCO is particularly effective at reducing odor-causing volatile organic compounds (VOCs) which include toxic chemical vapors like formaldehyde and toluene.
The Other Two Thirds
Airborne contaminants can be divided roughly into thirds. Conventional filtration is effective against particulates, like dust, but has no effect on the other two thirds. APCO is proven to safely reduce both VOCs and biological contaminants inside the air system and throughout the home.



No Worries!
APCO are so confident in the quality of their design and manufacturing that this product comes with a lifetime warranty on all parts except the UV lamp (which needs to be replaced every one or two years depending on model).
Ozone-Free
Many air purifiers that claim to reduce odors do so by generating harmful ozone. APCO not only does not produce ozone, it actually removes it from the air!

What the System Does

Odor Control
Let's face it, no one wants visiting friends or family to smell the cat box or last night's garlic sauce. You could use a spray or a candle but those things just perfume the air. APCO actually removes odors by transforming odor-causing VOC molecules into harmless water vapor and CO2. So keep the cat, and fry that fish!







Indoor Air Quality
According to the EPA indoor air pollution is often five times worse than outdoor and represents a significant health risk. An APCO whole-house air purifier improves indoor air quality by destroying odor-causing and potentially toxic VOCs, while sterilizing mold, bacteria, viruses, and allergens from the air stream.

How the System Works
Advanced Photocatalytic Oxidation

APCO detoxes the air with a process called photocatalytic oxidation (PCO), a technology similar to the catalytic converter on your car’s exhaust. UV-C light reacts with titanium dioxide infused into the carbon which effectively disintegrates the captured contaminants, leaving only harmless water vapor and CO₂ which are released back into the air. This process leaves the carbon cells clean so they never fill up or need to be replaced. The result is clean, odor-free air throughout the home.
Germ-Killing Power of UV-C Light
For over a century scientists have known about the germ-killing properties of UV-C light. Because this frequency of light is filtered out by the Earth's atmosphere microorganisms have no defense against it. It works by scrambling their DNA which prevents them from reproducing.

APCO Models & Prices
Include Installation
TUV-APCO

APCO is the award-winning air cleaning technology that combines the power of UV-C light with activated carbon and photocatalytic oxidation (PCO). APCO eliminates odors, toxic VOCs, and microbial contaminants from the air and air system. It comes with a 1 year lamp.

TUV-APCO-DI

APCO is the award-winning air cleaning technology that combines the power of UV-C light with activated carbon and photocatalytic oxidation (PCO). APCO eliminates odors, toxic VOCs, and microbial contaminants from the air and air system. TUV-APCO-DI features a second remote mounted UV lamp for complete coverage. It comes with a 1 year lamps.

Book Our Services Right Away!